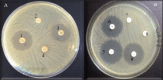

Molecular identification of antibiotic-resistant and virulent Escherichia coli and Staphylococcus aureus isolated from dogs in Southern Benin
- PMID: 41069727
- PMCID: PMC12506730
- DOI: 10.5455/javar.2025.l907
Molecular identification of antibiotic-resistant and virulent Escherichia coli and Staphylococcus aureus isolated from dogs in Southern Benin
Abstract
Objective: Antibiotic resistance is a worldwide health challenge. Close interaction with dogs carrying antibiotic-resistant zoonotic agents poses a risk to human health. The present study aimed to characterize antibiotic-resistant Escherichia coli (E. coli) and Staphylococcus aureus (S. aureus) isolated from dogs in Southern Benin.
Materials and methods: A total of 336 swabs (112 buccal, 112 nasal, and 112 rectal) from 112 dogs living in the communes of Abomey-Calavi and Cotonou were analyzed for E. coli and S. aureus presence. Bacterial isolates were tested for antibiotic (penicillins, tetracyclines, aminoglycosides, cephalosporins, sulfonamides, and macrolides) susceptibility using the disc diffusion method, and antibiotic-resistant strains were characterized by the polymerase chain reaction method.
Results: A 41.07% and 20.53% of dogs harbored E. coli and S. aureus, respectively. Escherichia coli and S. aureus isolates showed resistance to penicillin (100% and 81.48%), tetracycline (44.64% and 59.26%), and other antimicrobials tested. Escherichia coli isolates harbored resistance genes blaTEM (63.46%), tetA (62.50%), and strA-strB (55.56%). tetK (100%), tetM (100%), and blaZ (82.61%) were present in S. aureus isolates. Escherichia coli strains harbored virulence genes fimH (61.54%), kpsMTII (26.92%), fyuA (19.23%), and eae (1.92%), whereas 20.83% of S. aureus strains harbored pvl and fnbA.
Conclusion: The results of the current study reveal the urgent need for stricter controls on antibiotic use. Implementing guidelines, responsible prescribing, and increasing public awareness are crucial steps to address this problem.
Keywords: Benin; Dogs; Escherichia coli; Prevalence; Staphylococcus aureus.
© The authors.
Conflict of interest statement
The authors declare that they have no conflicts of interest.
Figures

References
-
- Ateudjieu J, Fodjo JNS, Ambomatei C, Tchio-Nighie KH. BissekA-C ZK. Zoonotic diseases in sub-Saharan Africa: a systematic review and meta-analysis. Zoonotic Dis. 2023;3(4):251–65. https://doi.org/10.3390/zoonoticdis3040021.
-
- Pakbin B, Brück WM, Rossen JWA. Virulence factors of enteric pathogenic Escherichia coli: a review. Int J Mol Sci. 2021;22(18):9922. https://doi.org/10.3390/ijms22189922. - PMC - PubMed
-
- Bitrus A, Olabode M, Abbas M, Goni MD. Staphylococcus aureus: a review of antimicrobial resistance mechanism. Vet Sci Res Rev. 2018;4:43–54. https://doi.org/10.17582/journal.vsrr/2018/4. 2.43.54.
-
- Yu D, Banting G, Neumann NF. A Review of the taxonomy, genetics, and biology of the genus Escherichia and the type species Escherichia Coli. Can J Microbiol. 2021;67(8):553–71. https://doi.org/10.1139/cjm-2020-0508. - PubMed
-
- OMS Plan d’action mondial pour combattre la résistance aux antimicrobiens Available via. https://www.who.int/fr/publications-detail/9789241509763. (accessed 24 March 2024)